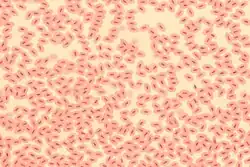

Sang
.jpg)
| Système | |
|---|---|
| Comprend |
| Nom latin |
Sanguis |
|---|---|
| MeSH |
D001769 |
| TA98 |
A12.0.00.009 |
| TA2 |
3892 |
| FMA |
9670 |



Le sang est un liquide biologique vital qui circule continuellement dans les vaisseaux sanguins et le cœur, notamment grâce à la pompe cardiaque. Il est composé d'un fluide aqueux, le plasma, et de milliards de cellules, principalement les globules rouges, qui lui donnent sa couleur.
Ce liquide transporte le dioxygène (O2) et les éléments nutritifs nécessaires aux processus vitaux de tous les tissus du corps, ainsi que les déchets, tels que le dioxyde de carbone (CO2) ou les déchets azotés, vers les sites d'évacuation (reins, poumons, foie, intestins). Il permet également d'acheminer les cellules et les molécules du système immunitaire vers les tissus, et de diffuser les hormones dans tout l’organisme.
Chez l'adulte, c’est la moelle osseuse qui produit les cellules sanguines au cours d’un processus appelé l'hématopoïèse. Hors de la moelle, le sang est dit périphérique.
Origines du sang
Le sang est à première vue reconnaissable à l'ouverture des tout premiers vertébrés, comme la lamproie marine (Petromyzon marinus), espèce vivant encore actuellement. Dans la classification phylogénétique, depuis le Cambrien (environ 500 millions d'années), les Petromyzontidae présentaient déjà une hémoglobine permettant le transport du dioxygène vers les tissus, dans une circulation fermée, où le sang pouvait conserver ses propriétés. Normalement inapparent, c'est par son écoulement (le saignement), qu'il a commencé à être reconnu et identifié par ses particularités sensorielles (couleur, odeur, goût, toucher) avant les analyses physico-chimiques plus spécifiques. En cas de brèche ou d'effraction des vaisseaux, ses propriétés de fluide mobile coloré se transforment spontanément, rapidement et irréversiblement, le sang versé signant ainsi l'atteinte de l'intégrité d'un organisme vivant évolué — et par là donc, sa vulnérabilité — et cette caractéristique participe depuis, au cycle des comportements de prédation de très nombreuses espèces.
Chez les chordés
Chez les chordés, l'oxygène est transporté par l'hémoglobine, qui colore le sang en rouge. Il devient rouge clair lors de l’oxygénation dans les poumons ou les branchies. De couleur rouge dans les artères, il devient ensuite rouge foncé quand il perd son dioxygène au profit des tissus. En observant les veines au travers des peaux claires, le sang paraît bleu mais il est bien rouge sombre, même à l’intérieur des veines. C'est la peau qui agit comme un filtre, ne laissant passer que le bleu[1].
Le cœur met le sang en circulation dans tout l’organisme. Il passe par les poumons (petite circulation) pour se charger en dioxygène et évacuer le dioxyde de carbone, et circule ensuite à travers le corps via les vaisseaux sanguins (grande circulation). Il libère son dioxygène et prend en charge le dioxyde de carbone au niveau des capillaires sanguins qui sont les plus petits vaisseaux sanguins de l’organisme. Dans son état désoxygéné, sa couleur rouge est moins brillante (comme dans le cas du sang veineux périphérique, par exemple).
Le sang véhicule les déchets métaboliques des organes qui sont toxiques au-delà d'une certaine concentration. Le foie et les reins extraient ces déchets, évacués dans la bile et les urines.
Chez d'autres animaux
Chez les arthropodes (l'embranchement des arthropodes est de très loin celui qui possède le plus d'espèces et le plus d'individus de tout le règne animal, comme les crustacés, les arachnides et les insectes), mais aussi chez les mollusques, c'est l'atome de cuivre (et non de fer) qui transporte l'oxygène dans l'hémocyanine, d'où un sang bleu-vert[2].
Composition
En tant que tissu conjonctif liquide, le sang contient des éléments cellulaires et des substances fondamentales, sans fibres, contrairement aux tissus conjonctifs solides. Son pH varie entre 7,35 et 7,45[3]. Sa couleur provient de l'hémoglobine (protéine comportant quatre hèmes).
Éléments figurés
- Érythrocytes ou hématies ou globules rouges (à peu près 99 %). Elles ne possèdent ni noyau ni organites chez les Mammifères, mais chez d'autres groupes comme les Oiseaux c'est le cas.
Elles contiennent l’hémoglobine (1⁄3 des composants du cytoplasme) qui permet de transporter l’oxygène ainsi que le fer mais aussi le dioxyde de carbone ou le monoxyde de carbone. Elles contiennent également des enzymes leur permettant de fonctionner et de survivre. Leur durée de vie est de 120 jours et leur destruction est opérée au niveau de la rate et l'hémoglobine est récupérée par les macrophages du foie, de la rate et de la moelle osseuse.
- Leucocytes ou globules blancs (0,2 %), qui font partie du système immunitaire et permettent la destruction des agents infectieux. Les leucocytes sont un ensemble hétéroclite de cellules :
- les granulocytes ou polynucléaires (neutrophiles, éosinophiles, basophiles) ;
- les lymphocytes ;
- les monocytes.
- Thrombocytes ou plaquettes (0,6 - 1,0 %), responsables de la formation du clou plaquettaire précédant la coagulation sanguine. Ils ne contiennent pas de noyau ; ce sont des fragments de cellule provenant de leurs précurseurs, les mégacaryocytes.
Ces éléments figurés constituent 45 % du sang (voir hématocrite), ce sont toutes les cellules contenues dans le sang. Les 55 % restants constituent le plasma sanguin, un liquide jaunâtre qui est la phase liquide dans laquelle sont en suspension les éléments figurés.
Plasma sanguin
Le plasma est la composante liquide du sang dans laquelle baignent les éléments figurés. Il est constitué d’eau, d’ions et de différentes molécules qui sont ainsi transportées à travers l’organisme. Il faut encore le distinguer du sérum sanguin, liquide issu d'un caillot sanguin rétracté, dont la composition est un peu différente de celle du plasma sanguin, car dépourvu en particulier du fibrinogène.
Les principales molécules du soluté du plasma (le solvant étant l'eau qui est la principale composante du sang) sont :
- le glucose ;
- les lipides ;
- les protéines (qui peuvent être séparées par électrophorèse en plusieurs pics : albumine, α1, α2, β, γ), dont les principales sont :
- l'albumine, qui dans la pression oncotique joue le rôle de transporteur (de bilirubine, d'hormones, de médicaments, d'ions, etc.),
- les immunoglobulines du système immunitaire,
- des protéines du complément, qui ont un rôle majeur dans l’initiation de la réponse immunitaire et de l’inflammation,
- des protéines de la coagulation sanguine (les facteurs de coagulation).
Certains de ces éléments sont des hormones, pouvant être des protéines, des acides aminés modifiés, des stéroïdes, ou des lipides modifiés (dont les prostaglandines et les thromboxanes).
Autres composants potentiels :
- microbes et parasites ;
- molécules d'origine exogène : médicaments, résidus de pesticides, métaux lourds et métalloïdes, radionucléides sous forme ionique libre ou associée à des protéines ou d'autres molécules transporteuses (dont chélatrices). En 2010, il a été proposé de compléter les bilans sanguins et bilans de santé classiques par un profil métallique[4][réf. à confirmer].
Fonctions
Une fonction de transport : le sang (liquide circulant) assure une double fonction de transport, il distribue l’oxygène et les nutriments nécessaires au fonctionnement et à la survie de toutes cellules du corps et en même temps, récupère le dioxyde de carbone et les déchets (urée) qui résultent de l’activité de tout organe vivant.
Le sang est constitué d’un liquide presque incolore très riche en eau (le plasma) dans lequel baignent des globules rouges, des globules blancs et des coagulants.
Le sang s’enrichit en nutriments et reçoit une grande partie de l’eau contenue dans les aliments.
Le sang se débarrasse des déchets collectés (dioxyde de carbone, etc.) et s’enrichit en oxygène dans les poumons.
Le sang se débarrasse de son excès d’eau : l’urine (de l’eau contenant des déchets) est « fabriquée » par les reins.
Seuls les globules rouges, qui contiennent de l’hémoglobine, donnent au sang sa couleur rouge. Leur nombre est considérable (4 500 000 par millimètre cube de sang) et leur fonction essentielle est le transport du dioxygène et du dioxyde de carbone. Ces derniers se fixent en effet sur l’hémoglobine, facilités par sa forme de disque biconcave (région centrale : 0,8 μm, région périphérique : 2,6 μm) la plus apte à une fixation maximale.
Il contribue également à la régulation de nombreuses fonctions : pression artérielle, pression oncotique, régulation du pH, maintien de la température corporelle, etc.
Étude
Le sang peut être fractionné entre ses différents composants de deux façons, selon l'utilisation d'anticoagulant.
Si le sang est prélevé sur un anticoagulant (comme l'EDTA), la centrifugation sépare 2 phases, un surnageant jaunâtre, le plasma, et un culot, constitué par les hématies, dont la hauteur dans le tube définit l'hématocrite, normalement de 45 %. À l’interface entre ces 2 phases, on peut observer un mince anneau blanchâtre contenant les leucocytes et les plaquettes. Une simple agitation permet de mélanger tous ces composants et de les remettre en suspension.
Si le sang est prélevé sans anticoagulant, on obtient un surnageant jaunâtre, le sérum, et un culot, contenant les hématies emprisonnées dans un réseau de fibrine. Les hématies ne peuvent pas être remises en suspension.
Santé

L’hématologie est la spécialité médicale chargée de l’étude des affections de la circulation sanguine :
- Les principales affections hématologiques sont :
- l’hémophilie est une maladie génétique ;
- les leucémies (ou « cancers du sang ») ;
- le sang peut également être « intoxiqué » par de nombreux composés dont le monoxyde de carbone, ou encore le plomb (qui cause le saturnisme).
- Sang et maladies infectieuses :
- paludisme : le plasmodium (parasite) colonise les hématies.
Certaines maladies peuvent être transmises par transfusion sanguine, dont notamment l’hépatite C et le sida (le virus (VIH) peut se transmettre par contact entre le sang d’une personne et le sang ou/et le sperme).
Pour cette raison, dans certains contextes, on traite les objets tachés de sang comme un danger biologique.
- Hémorragies :
- les lésions corporelles peuvent entraîner des fuites importantes de sang (hémorragies). Les thrombocytes servent à coaguler le sang dans les plaies mineures, mais les plaies majeures doivent être réparées tout de suite pour prévenir l’exsanguination. Des plaies internes, passant parfois inaperçues, peuvent causer des hémorragies graves.
- Les transfusions sanguines :
- les pertes importantes de sang, traumatiques ou non (par exemple lors d’une chirurgie), ou une maladie sanguine telle l’anémie ou la thalassémie, peuvent nécessiter des transfusions de sang. La découverte des groupes sanguins ABO par Karl Landsteiner, en réduisant très considérablement les nombreux accidents qui pouvaient survenir lors de leur réalisation, en a facilité la pratique.
Plusieurs pays ont des banques de sang pour répondre au besoin de sang à transfuser. Une personne transfusée doit être d’un groupe sanguin compatible avec celui du donneur (transfusion iso-groupe) ; - il est possible de transfuser des culots globulaires (« sang déleucocyté » : dans ce cas, seules les hématies sont conservées, afin de minimiser les risques de réaction de la part du receveur) ou des plaquettes seules ;
- le matériel utilisé pour les dons est à usage unique, et chaque don est maintenant[Quand ?] soumis à une batterie de tests visant à dépister des maladies comme le VIH ou l’hépatite C. Les risques de transmission de maladies infectieuses au receveur sont ainsi réduits au minimum du savoir-faire ;
- une poche de sang ne se conservant qu’un peu plus d’un mois (42 jours pour les concentrés érythrocytaires en SAG Mannitol[Quoi ?], 5 jours pour les concentrés de plaquettes) et le sang ne pouvant pas se fabriquer artificiellement, le don est essentiel au maintien des stocks de sang.
- les pertes importantes de sang, traumatiques ou non (par exemple lors d’une chirurgie), ou une maladie sanguine telle l’anémie ou la thalassémie, peuvent nécessiter des transfusions de sang. La découverte des groupes sanguins ABO par Karl Landsteiner, en réduisant très considérablement les nombreux accidents qui pouvaient survenir lors de leur réalisation, en a facilité la pratique.
- La pression artérielle est un important outil de diagnostic.
Sang chez l’être humain

Chez l'humain, le sang représente en moyenne 7 à 8 % de sa masse corporelle.
Son parcours à travers le corps humain peut être résumé en une série de différentes étapes.
Le cycle commence après un passage au niveau des poumons. Le sang, alors riche en dioxygène, est envoyé vers le cœur par quatre veines pulmonaires : les veines pulmonaires inférieure et supérieure droite, et inférieure et supérieure gauche. Une fois à l'intérieur, il transite par l'oreillette et le ventricule gauche avant de rejoindre l'aorte, le plus gros vaisseau sanguin de l'organisme, puis les organes en empruntant l'ensemble du réseau artériel. Les artères, par un système de dilatation pariétale permettant la variation de leur volume, représente le réservoir de pression du système cardio-vasculaire. Une fois le dioxygène distribué le sang, alors chargé en dioxyde de carbone libéré par les organes, va retourner vers le cœur via le réseau veineux puis les deux veines caves, inférieure et supérieure. La proportion volumique de sang dans les veines est plus grande que celle dans les artères, elles servent de réservoir sanguin à la pompe cardiaque. Après un passage par l'oreillette droite puis le ventricule droit, il va finalement être ramené par les artères pulmonaires au niveau des poumons afin d'y être de nouveau oxygéné, entamant ainsi un nouveau cycle. L'ensemble du flux sanguin passe de cette manière par les poumons, assurant une oxygénation constante de l'organisme.
Le sang circule, toujours dans le même sens, à l’intérieur d’un circuit entièrement clos formé de vaisseaux sanguins de divers calibres, répartis dans tout le corps. Les contractions du cœur assurent la circulation du sang. Quatre valves dont deux atrio-ventriculaires (entre l'oreillette et le ventricule du cœur) et deux ventriculaires (entre le ventricule du cœur et l'artère) assurent la circulation unidirectionnelle du sang dans l'organisme.
Le passage du sang des oreillettes aux ventricules est appelé systole auriculaire, celui des ventricules vers l'aorte ou l'artère pulmonaire systole ventriculaire. La diastole, période de relâchement du myocarde, permet quant à elle le remplissage en sang des ventricules et oreillettes.
Le cœur est une pompe foulante et aspirante qui éjecte le sang dans les vaisseaux de l’appareil circulatoire et qui contribue au retour veineux.
Quelques chiffres
Dans le corps d’un homme de 65 kg, circulent 5 à 6 litres de sang, 4 à 5 litres chez une femme (augmentant jusqu'à 5 à 6 litres en cours de grossesse)[5], dans celui d’un enfant, environ 3 litres et 250 millilitres pour un nouveau-né.
Dans la moelle rouge des os, naissent chaque jour environ :
- 200 milliards de globules rouges[6] ; et l'organisme doit en produire 2 millions de nouveaux par seconde afin d'en garder constante la quantité totale ;
- plusieurs milliards de globules blancs. Toutefois, ils sont 600 fois moins nombreux que les globules rouges (pour un seul globule blanc, il y a environ 30 plaquettes et 600 globules rouges).
Le sang est composé de 54 % de plasma, 45 % de globules rouges (encore appelés hématies) et 1 % de globules blancs (aussi appelés leucocytes) et de plaquettes (ou thrombocytes)[7].
Un millilitre de sang contient 0,5 mg de fer[8].
Au niveau mondial, l'exportation de sang humain et de sérum a représenté un marché de 127,6 milliards de dollars américains en 2015, en hausse de 41,9 % depuis 2009 (soit plus que les ventes à l'exportation de l’industrie aérospatiale)[9].
Symbolique et croyances
Sur le plan religieux
Le christianisme a rapidement abandonné les règles de la cacherout, mais l’interdit du sang issu des lois noahides est repris dans les Actes des Apôtres 15[10] : « Lorsqu’ils eurent cessé de parler, Jacques prit la parole, et dit : […] je suis d’avis qu’on ne crée pas des difficultés à ceux des païens qui se convertissent à Dieu, mais qu’on leur écrive de s’abstenir des souillures des idoles, de l’impudicité, des animaux étouffés et du sang ». L'interdiction des animaux étouffés va dans le même sens que l'interdiction du sang : un animal étouffé (non égorgé) reste rempli de son sang.
Aussi, certains groupes religieux chrétiens l'appliquent également, tels les Témoins de Jéhovah qui vont jusqu’à prohiber la transfusion sanguine, présentée comme une violation de la loi divine[11].
Sang menstruel
La perte de sang liée à la menstruation est un phénomène physiologique « spectaculaire », à l'origine de nombreuses croyances et tabous culturels ; Cesare Lombroso la liait ainsi à la criminalité féminine[12].
Masters et Johnson rappellent :
« En 1878, le prestigieux British Médical Journal édita une série de lettres de médecins qui donnaient des « preuves » que le contact d’une femme qui avait ses règles pouvait abîmer le jambon qu’elle avait touché[13]. »
Théorie des humeurs
Le sang fait partie des quatre humeurs d'Hippocrate :
Bibliographie
Histoire et anthropologie
- Gérard Tobelem, Histoires du sang, Place des éditeurs, , 403 p. (ISBN 978-2-262-04388-9, lire en ligne)
- Jacques-Louis Binet, Le sang et les hommes, Éditions Gallimard, (réimpr. 2001), 128 p. (ISBN 2070761568, présentation en ligne).
- Jean Héritier, La sève de l'homme : De l'âge d'or de la saignée aux débuts de l'hématologie, Éditions Denoël, , 180 p. (ISBN 978-2207233283)
- Jean-Paul Roux, Le sang: mythes, symboles et réalités, Fayard, , 407 p. (ISBN 978-2-213-02090-7, lire en ligne)
- Jean Bernard, La légende du sang, Flammarion, , 287 p. (ISBN 978-2-08-035152-4, lire en ligne)
- Vanessa Rousseau, Le goût du sang, Armand Colin, , 316 p. (ISBN 9782200269135)
Sciences
- Claude Jacquillat, Le Sang, PUF, coll. « Que sais-je ? », , 127 p. (ISBN 978-2130425472)
- Chantal Beauchamp, Le sang et l'imaginaire médical : Histoire de la saignée aux xviiie et xixe siècles, Desclée de Brouwer, , 270 p.
- Pierre Flourens, Histoire de la découverte de la circulation du sang, Garnier Frères, Libraires, (1re éd. 1801), 283 p. (lire en ligne)
Littérature
- Curzio Malaparte (trad. René Novella, préf. Alain Sarrabayroush), Sang et autres nouvelles, Flammarion, , 153 p. (ISBN 2080706780, lire en ligne)
Notes et références
- ↑ (en) Alwin Kienle, Lothar Lilge, I. Alex Vitkin, Michael S. Patterson, Brian C. Wilson, Raimund Hibst, and Rudolf Steiner, « Why do veins appear blue? A new look at an old question », Applied Optics, vol. 35, no 7, , p. 1151-1160 (PMID 21085227, DOI 10.1364/AO.35.001151, lire en ligne).
- ↑ « Le sang des animaux est-il toujours rouge ? », Planète, sur Futura-Sciences (consulté le ).
- ↑ Anatomie et Physiologie de Elaine N. Marieb 8e Édition en français, page 732.
- ↑ Jean-Pierre Goullé, Elodie Saussereau, Loïc Mahieu, Daniel Bouige, Michel Guerbet, Christian Lacroix (2010) « Une nouvelle approche biologique : le profil métallique » ; Annales de Biologie Clinique, Volume 68, Numéro 4, 429-440, juillet-août 2010 ; DOI 10.1684/abc.2010.0442 (résumé).
- ↑ Principes d'anatomie et de physiologie humaine, 4e édition de Boeck de Tortora, Derrickson, page 716.
- ↑ Doriane Dab, Du Big bang à la guérison, Éditions Quintessence, (ISBN 978-2-913281-29-5, lire en ligne)
- ↑ Alain Cosson & Jacques Rouffy, « Sang, composition et propriétés », sur UNIVERSALIS (consulté le )
- ↑ (en) « Iron Deficiency Without Anemia – Common, Important, Neglected », sur oatext.com (consulté le )
- ↑ (en) Daniel Workman, « World’s Top Exports Report Card for Products and Countries », sur worldstopexports.com, (consulté le ).
- ↑ Selon Hyam Maccoby dans Paul et l'invention du christianisme ou François Blanchetière et Emmanuelle Main dans l'émission Les origines du christianisme, Concile à Jérusalem.
- ↑ Massimo Introvigne, Les Témoins de Jéhovah, Éditions du Cerf, , p. 98.
- ↑ Hilde Olrik. « Le sang impur. Notes sur le concept de prostituée-née chez Lombroso ». In: Romantisme, 1981, no 31. Sangs. p. 167-178.
- ↑ Masters William, Johnson Virginia, Kolodny Robert (en), Amour et sexualité : mieux vivre sa vie sexuelle dans le monde d'aujourd'hui, Interéditions, 1987.
Voir aussi
Articles connexes
Liens externes
- Ressources relatives à la santé :
- Ressource relative à la recherche :
- Notices dans des dictionnaires ou encyclopédies généralistes :
- « Sang », sur le dictionnaire de l’Académie nationale de médecine
- Sangs. Romantisme, 1981, no 31.
- Le sang, c'est quoi ?, sur le site de l'Établissement français du sang.
- Portail de l’hématologie
- Portail de la biologie